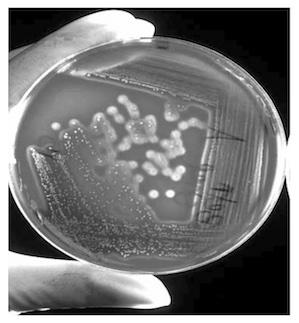

автордың кітабын онлайн тегін оқу Микробиология и микология. Особо опасные инфекционные болезни, микозы и микотоксикозы
Р. Т. Маннапова
Микробиология и микология. Особо опасные инфекционные болезни, микозы и микотоксикозы
Учебник
Издание второе,
переработанное и дополненное
Информация о книге
УДК 619:579(075.8)
ББК 48.7:28.4я73
М23
В оформлении обложки использованы изображения: grebcha, Dusan Petkovic, W_NAMKET, Dr. Norbert Lange, Rattiya Thongdumhyu, science photo, OlgaReukova, Lesny Ludek, Jarabogu, Stastny_Pavel, Have a nice day Photo, David Litman, Komsan Loonprom, Konstantin Kolosov, Zaharia Bogdan Rares, Arogang, Niraelanor, MyFavoriteTime, Chadsikan Tawanthaisong, Budimir Jevtic, Monika Wisniewska, Red Confidential / Shutterstock.com
Автор:
Маннапова Р. Т.
Рецензенты:
Ларионова О. С., доктор биологических наук, доцент, заведующая кафедрой микробиологии, биотехнологии и химии Саратовского государственного аграрного университета им. Н. И. Вавилова;
Андреева А. В., доктор биологических наук, профессор, заведующая кафедрой инфекционных болезней, зоогигиены и ветсанэкспертизы Башкирского государственного аграрного университета.
Учебник состоит из четырех разделов. Первый раздел содержит подробный материал о возбудителях особо опасных инфекционных болезней животных. Второй раздел посвящен микозам и кормовым микотоксикозам. Они составлены и изложены по единому плану. Третий раздел посвящен микробиологии продуктов животного происхождения. В четвертом разделе ко всем описанным в учебнике инфекционным болезням, микозам и микотоксикозам приведены схемы лабораторной диагностики и их специфической профилактики. В конце книги представлены терминологический словарь, сведения об основоположниках микробиологии и иммунологии и лауреатах Нобелевской премии.
Предназначен для подготовки специалистов с учетом требований программы ФГОС ВО по направлению 36.05.01 «Ветеринария», а также при подготовке магистров/бакалавров по направлению 36.04.01/36.03.01 «Ветеринарно-санитарная экспертиза».
УДК 619:579(075.8)
ББК 48.7:28.4я73
© Маннапова Р. Т., 2018
© Маннапова Р. Т., 2025, с изменениями
© ООО «Проспект», 2025
Посвящается светлой
памяти моих родителей —
Тимергалея Фахразетдиновича
и Нурзиды Динисламовны
Рафиковых
ПРЕДИСЛОВИЕ
Учебник «Микробиология и микология» подготовлен для обучения специалистов с учетом требований программы ФГОС ВО по направлению 36.05.01 «Ветеринария», а также при подготовке магистров/бакалавров по направлению 36.04.01/36.03.01 «Ветеринарно-санитарная экспертиза». Он может быть использован при проведении лабораторно-практических, факультативных занятий, выполнении научных исследований, в нем много внимания отводится самостоятельной работе студентов.
Учебник подготовлен в удобной форме как для студентов, так и для преподавателей дисциплины, ибо составлен с учетом региональных особенностей, современного состояния животноводства в целом по Российской Федерации, а также современных международных требований для подготовки востребованных конкурентоспособных специалистов для сельского хозяйства в условиях рыночной экономики, в частности ветеринарных врачей и ветеринарно-санитарных экспертов. По всем инфекциям, предусмотренным типовой и рабочей программой дисциплины микробиология и микология по направлениям подготовки 36.05.01 «Ветеринария» и 36.04.01/36.03.01 «Ветеринарно-санитарная экспертиза», в учебнике представлены схемы лабораторной диагностики и специфической профилактики инфекционных болезней, микозов и микотоксикозов. Учебник поможет студентам в изучении возбудителей особо опасных инфекционных болезней, микозов и микотоксикозов, лучшем освоении материалов, выносимых на лабораторно-практические занятия и на самостоятельное изучение. Все изложенные болезни оформлены по общей схеме: определение болезни, возбудитель, его морфология, культуральные, биохимические, токсигенные и антигенные свойства, патогенность и патогенез, устойчивость, диагностика, дифференциальная диагностика, патологическая анатомия, лечение, иммунитет и специфическая профилактика.
Учебник составлен в классическом стиле, для наглядности снабжен иллюстрациями (в виде цветных и черно-белых фотографий, электроннограмм) и таблицами, отражающими краткие сводки по ключевым аспектам инфекционных болезней животных, микозов и микотоксикозов. Надеемся, что он в той или иной степени удовлетворит запросы студентов, аспирантов и преподавателей, научных сотрудников, всех, кому он адресован.
Автор выражает искреннюю благодарность рецензентам за ценные замечания и пожелания по улучшению учебника и всем, кто оказал содействие в его подготовке.
Ваши замечания и пожелания присылайте по адресу: 127434, г. Москва, ул. Тимирязевская, 49, Российский государственный аграрный университет – МСХА имени К. А. Тимирязева, кафедра микробиологии и иммунологии, Р. Т. Маннаповой.
Раздел I
ОСОБО ОПАСНЫЕ ИНФЕКЦИОННЫЕ БОЛЕЗНИ
Глава 1. ГРАМПОЛОЖИТЕЛЬНЫЕ КОККИ
1.1. Возбудители стафилококкозов животных
Стафилококкозы — бактериальные инфекции, характеризующиеся гноеродными процессами различной этиологии, вызванными патогенными стафилококками.
Стафилококк обнаружен Р. Кохом1 (1878), выделен из гноя фурункула человека Л. Пастером (1880), обстоятельно изучен Ф. Розенбахом (1884).
Стафилококки подразделяются на три вида: Staphilococcus аureus — патогенные; S. epidermidis — условно патогенные, постоянные обитатели кожи и слизистых оболочек; S. Saprophyticus — непатогенные (род Staphylococcus семейство Micrococcaceae).
Патогенные стафилококки проявляются в виде абсцессов, фурункулов, карбункулов, маститов, метритов, пневмонии, сепсиса. Могут вызывать пищевые отравления людей.
Лабораторная диагностика стафилококкозов основана на результатах бактериологического исследования, которая включает бактериоскопию, выделение чистой бактериальной культуры и биопробу.
Для прижизненной диагностики при стафилококкозах в лабораторию направляют раневой экссудат, гной; при маститах — пробы молока. Раневой экссудат, гной берут стерильным ватным тампоном с палочкой, вставляют в стерильную пробирку и упаковывают. Жидкий экссудат, невскрытый абсцесс можно отсосать стерильной иглой со шприцем и слить в стерильную пробирку. При подозрении на сепсис в лабораторию направляют кровь. Для посмертной диагностики направляют кусочки пораженных тканей и органов, кровь.
Морфология. Стафилококки имеют шаровидную форму. Располагаются часто в виде неправильных бессистемных скоплений. В мазках из бульонных культур имеют вид микро- или диплококков, из агаровых культур — расположены в виде скоплений, напоминающих гроздь винограда. Диаметр кокков 0,5–1,5 мкм. Грамположительны (рис. 1.1.1), спор не образуют, особо патогенные штаммы могут образовывать капсулу. Неподвижны.

Рис. 1.1.1. Staphylococcus aureus: 1 — чистая культура, окраска по Граму; 2 — колонии на кровяном агаре; 3 — строение клетки: а — клеточная стенка, б — цитоплазматическая мембрана, в — нуклеоид, г — мембранные структуры внутри нуклеоида; 4 — мазок из патологического материала
Культуральные свойства. Стафилококки хорошо развиваются на обычных питательных средах с рН 7,2–7,4 при температуре 30–37 °С в аэробных и анаэробных условиях (факультативные анаэробы). При загрязнении материала посторонней микрофлорой используют селективные питательные среды: солевой мясо-пептонный агар (МПА), мясо-пептонный бульон (МПБ) с 8–10% хлорида натрия, желточно-солевой агар (ЖСА), 3,5% МПА с добавлением 3 мл 0,1%-ного раствора кристаллвиолета (патогенные стафилококки образуют колонии фиолетового или оранжевого цвета). На МПБ растут интенсивно, вызывают равномерное помутнение среды, образуют рыхлый осадок. Иногда при достаточной аэрации образуют поверхностную пленку. На плотных средах стафилококки растут в виде выпуклых, с ровными краями непрозрачных колоний правильной круглой формы диаметром 2–7 мм. При комнатной температуре, широкой аэрации и рассеянном свете стафилококки вырабатывают золотистые, белые, лимонно-желтые и другие пигменты. Лучшая среда для выделения стафилококка — кровяной агар, где они вызывают гемолиз (рис. 1.2.1).
Биохимические свойства. Применяются для определения патогенно сти стафилококков. Они ферментируют многие углеводы. Штаммы, ферментирующие маннит, являются патогенными (но эта способность нестабильна!). Ферментацию маннита определяют путем посева его на МПБ, содержащий 0,5% маннита, индикатор Андрэдэ + газовки (пробирки Уленгута для улавливания газа). После 1–2-суточной инкубации при температуре 37 °С среда с патогенным штаммом микроба краснеет, в газовках иногда скапливаются пузырьки газа.
Патогенные стафилококки обладают способностью коагулировать плазму крови. Плазмокоагулязную активность определяют в специальной реакции плазмокоагуляции (РПК). Коагулаза — фермент стафилококков, который коагулирует плазму крови. Петлю бактериальной массы исследуемой культуры, снятой с поверхности агаровой среды, смешивают с 0,5 мл плазмы крови кролика (человека), не разведенной или разведенной стерильным физиологическим раствором в соотношении 1:4, инкубируют при 37 °С. Учет результата через 4 и 24 ч. Положительная реакция — образование сгустка.
Патогенные стафилококки продуцируют фибринолизин. Для выявления фибринолитической способности пробирки с положительными результатами плазмокоагулирования оставляют в термостате на несколько суток. При наличии фибринолизина коагулированная плазма разжижается.
Тест на гемолизин. Исследуемую культуру засевают на чашку Петри с 5%-ном кровяным агаром и инкубируют при 37 °С 24 ч. Лизис эритроцитов проявляется в виде светлой (альфа-гемолиз) или полупрозрачной (бета-гемолиз) зоны вокруг колоний. Гемолитическую активность можно определить путем посева исследуемой культуры в 1–5%-ной кровяной бульон, который после культивирования выделяющего гемолизин микроба становится прозрачным за счет лизиса эритроцитов.
Гемолититическая способность стафилококков бывает не всегда выраженной. Скрытую (потенциальную) способность стафилококков выявляют на 5%-ном кровяном МПА. По диаметру чашки Петри делают прямой полоской посев бета-гемолитического штамма стафилококка. Перпендикулярно этой полоске с двух сторон высевают по 4–5 испытуемых штаммов стафилококков. После суточного инкубирования в непосредственной близости к высеянному по диаметру бета-гемолитическому штамму стафилококка образуется зона гемолиза.
Стафилококки продуцируют лецитиназу. Для ее определения к расплавленному и остуженному до 50–60 °С МПА добавляют взбитые яичные желтки и тщательно перемешивают. После застывания делают посев испытуемой культуры. Лецитиноположительные штаммы стафилококка через 24–48 ч вокруг колоний образуют зону помутнения, окруженную радужным венчиком.
Тест на ДНКазу. Исследуемую культуру засевают «штрихом» на питательную среду с ДНК и культивируют при 37 °С 24 ч. Затем на поверхность среды с бактериальной культурой наливают 1 н. раствор соляной кислоты. Положительный результат — при гидролизе ДНК вдоль «штриха» культуры видна светлая зона (питательная среда с ДНК: в расплавленный МПА добавляют 10%-ный раствор ДНК до конечной 0,2%-ной концентрации, перемешивают, автоклавируют при 120 °С 15 мин и разливают в чашки Петри).
Патогенные стафилококки растут на среде с кристаллвиолетом, не патогенные не растут.
Биопроба, токсигенные свойства. Заражают лабораторных животных для подтверждения токсигенных свойств выделенного стафилококка. Патогенные стафилококки продуцируют несколько токсинов, обладающих разносторонним действием на организм:
• энтеротоксин — при попадании с пищей, с кормом в пищеварительный тракт вызывает пищевую токсикоинфекцию (биопроба на 4–8-недельных котятах, которым с молоком дают бульонную культуру стафилококка, при наличии токсина через 1–2 ч возникают симптомы гастроэнтерита и рвота);
• летальный токсин общего действия — при внутривенном введении бульонной культуры стафилококка кроликам через 15–30 мин наступает смерть животного с признаками острой токсемии: одышка, учащенное сердцебиение, парезы);
• некротический токсин — вызывает некроз тканей (при внутрикожном введении стафилококковой культуры кроликам на месте инъекции развивается омертвение кожи);
• гемотоксин — обладает выраженным гемолитическим действием (лизис эритроцитов); при посеве стафилококков на кровяной агар вокруг колоний образуются обширные зоны гемолиза;
• лейкоцидин — вызывает лизис лейкоцитов, гибель гематобластов костного мозга и нервных клеток;
• в стафилококковых культурах выделен также антикоагулянт, препятствующий свертыванию крови; гемагглютинины;
• стафилококковый экзотоксин, обезвреженный 0,3–0,5% формалином при температуре 37 °С в течение 7–28 суток, при парентеральном введении людям и животным обусловливает синтез специфического антитоксина, способного вступать в реакцию с токсином.
Профилактика: соблюдение зоогигиенических и санитарно-гигиенических условий, устранение витаминной недостаточности, предупреждение травматизма, систематические дезинфекции, своевременная обработка ран.
Схемы лабораторной диагностики и биопрепараты. См. приложения.
1.2. Возбудители стрептококкозов животных
1.2.1. Мастит коров
Стрептококкозы (streptococcosis) — инфекционное заболевание молодняка сельскохозяйственных животных, характеризующееся тяжелыми септическими явлениями, воспалением органов дыхания, желудочно-кишечного тракта и суставов. У взрослых животных проявляются эндометритами и маститами.
В патологии сельскохозяйственных животных наибольшее значение имеют следующие виды гноеродных стрептококков (род Streptococcus, семейство Streptococcaceae): а) S. agalactiae — возбудитель мастита коров; б) S. equi — возбудитель мыта лошадей; в) S. pneumoniaе — возбудитель стрептококковой (диплококковой) септицемии молодняка сельскохозяйственных животных: г) S. pyogenes — возбудитель гнойно-некротических процессов.
Мастит коров. Основной возбудитель — S. agalactiae. Но в этиологии мастита, кроме S. agalactiae, могут принимать участие до десятков других видов микроорганизмов, в том числе стрептококков, стафилококков, эшерихии, вульгарный протей. Мастит — это воспаление молочной железы коровы. Мастит у коровы возникает не только во время лактации. Это заболевание может развиться и во время сухостоя, когда животное отдыхает перед очередным отелом. Мастит у коров приводит к снижению продуктивности животных. Заболевание не только снижает количество молока у коровы, но также может сделать его непригодным для употребления. При сильном воспалительном процессе животное испытывает все последствия тяжелейшей интоксикации, кроме того, маститы негативно влияют на внутриутробное развитие плода и физиологическое состояние новорожденных телят. Лишенные молозива, телята не получают полноценную иммунную защиту. При болезнях вымени патогенные штаммы кишечной палочки и стафилококков легко передаются молодняку именно через молозиво, вызывая желудочно-кишечные и легочные заболевания и гибель приплода.
Мастит у коровы имеет несколько вариантов развития: полное выздоровление; переход в хроническую форму; скрытое воспаление; потеря четверти.
Формы мастита: субклинический и клинический.
Субклинический мастит — этот тип воспаления вымени нельзя заметить по внешним признакам. Для того чтобы провести диагностику этого мастита, необходимо провести лабораторное исследование — анализ на поражение калифорнийским мастит-тестом (CMT) и подсчет соматических клеток (SCC). Этот тип воспаления, в зависимости от возбудителя заболевания, может перейти в клинический или вылечиться самостоятельно.
Клинический мастит проявляется в легкой, умеренной, тяжелой и гангренозной форме. При легкой форме молоко выделяется хлопьями или комками и непригодно для употребления. Вымя при этом выглядит совершенно нормально. Чаще всего в такой форме заболевание во многих хозяйствах даже не диагностируется. При умеренной форме вымя отвердевает, краснеет, набухает и становится болезненным, температура воспаленной четверти повышается. Внешний вид молока также изменяется. Отек вызывается сгустками молока, которые блокируют молочные каналы. Как следствие, снижается продуктивность коровы. Для тяжелой формы мастита характерно следующее: молоко становится водянистым, похожим на сыворотку, может быть с примесью крови. Продуктивность коровы резко снижается. Инфекция способна вызывать снижение уровня кальция в крови, при этом у коров появляются симптомы молочной лихорадки (гипокальцемии). При таком мастите у животного все признаки сильной интоксикации. Гангренозную форму мастита можно диагностировать по охлаждению, голубоватому оттенку четверти. Мастит этого типа ведет к потере четверти вымени.
Причины мастита коров. Выделяют инфекционные факторы, приводящие к данному заболеванию, и неинфекционные. Среди болезнетворных микроорганизмов нередко встречаются патогенные стрептококки, стафилококки, а также микоплазмы, синегнойная и кишечная палочки, сальмонеллы и др. Чтобы микробы могли проникнуть в молочную железу коровы, бывает достаточно вытереть ее вымя грязным полотенцем или обмыть грязной водой. Также в случае инфицирования рук самой доярки у коровы может развиться мастит.
Если вымя было каким-либо образом травмировано, тогда также возникает мастит. Поэтому любые уколы, щипки, ссадины, удары, переохлаждение или обморожение могут стать причиной развития данного заболевания.
В сухостойный период воспаление вымени возникает под воздействием неблагоприятных факторов, снижающих общий иммунитет и резистентность организма и тканей вымени. Причиной могут служить антисанитарные условия содержания; сквозняки, неполноценное кормление, нарушение техники доения и порядка запуска. Неправильный запуск коров является причиной проникновения инфекции в ткани вымени и развития воспалительного процесса, который проявляется уже после отела.
Необходимо своевременно поставить диагноз «мастит».
Сухостойный период — оптимальный для проведения лечения коров от мастита, а также своевременной диагностики его скрытых форм. В этот период на мастит коров исследуют дважды: в самом начале, а затем за 10–15 дней до отела. Если корова здорова, в первые 20–30 дней сухостоя секрета много, он жидкий, серовато-белого цвета, без хлопьев, во второй половине сухостоя секрета мало (3–5 мл), он вязкий, тягучий, клейкий, желтовато-коричневого цвета. В любом случае, даже если видимых изменений в структуре вымени и качестве молочного секрета нет, необходимо сделать лабораторный анализ на скрытый мастит. Чаще всего мастит наблюдается в течение первых двух месяцев после запуска коровы и после отела.
Период запуска — самый ответственный. Необходимо следить за состоянием вымени. При любом покраснении проводится пробное доение четверти. В первый месяц запуска у здоровой коровы молоко жидкое, без изменения цвета. Если имеются хлопья, значит, животное заболело. Во второй месяц запуска вместо перегоревшего молока в вымени образуется секрет, по консистенции напоминающий мед. Его немного — 3–4 мл. Более жидкий секрет сероватого оттенка — признак мастита.
После отела необходимо проверить состояние молозива коровы (молозивный период длится 5–7 дней). Тест можно легко проделать в домашних условиях без помощи реактивов. Молозиво наливается в пробирку и ставится на час в холодильник. Если за это время жидкость расслоится — у коровы мастит и кормить теленка корова не должна.
Лечение мастита. Многое зависит от того, какая форма мастита развилась. При первых симптомах заболевания нужно сразу начать лечение мастита у коров. При развитии хронической формы удои значительно сокращаются, а само заболевание может дойти до гангрены вымени. Больное животное нужно отделить от стада и поселить в чистое и сухое стойло. Сочные корма давать не следует, а лучше свежее сено. Сдаивание проводят каждые 6–8 ч в отдельную посуду, выдоенное молоко потом дезинфицируют и выливают. Доить на пол или выливать непродезинфицированное молоко нельзя, так как болезнетворные микробы будут распространяться на вымя больного животного и на здоровых особей.
Обязательное лекарство при маститах любой формы — антибиотики. Они могут быть как широкого спектра действия, так и специфическими. Назначаются после определения чувствительности к ним микроорганизмов. Также применяют противовоспалительные препараты и делают на вымя различные аппликации, чтобы здоровье животного восстановилось быстрее. Во время лактации антибиотиками лечить коров нельзя, поскольку в этом случае молоко будет непригодно для использования. При остром воспалительном процессе можно назначить промывание молочных цистерн дезинфицирующими растворами или настойками трав.
Профилактика мастита. Начинать профилактику следует с улучшения гигиены содержания и кормления животных, а также постоянного обследования оборудования и коров. Заболевших животных следует изолировать от здоровых, а лечение проводить своевременно и в полной мере. Очень важно снизить возможность проникновения болезнетворных микроорганизмов в вымя. Для этого перед каждой дойкой соски необходимо обмывать теплой водой. После дойки на кончике соска остается молочная капля — она также может служить источником инфекции, так как молоко — прекрасная среда для размножения бактерий. Сосковое отверстие после доения остается открытым от 30 мин до 2 ч, и времени этого вполне достаточно, чтобы болезнетворные микробы проникли внутрь. После дойки соски животного также необходимо дезинфицировать, для этого подойдет 1%-ный раствор хлористого йода (1 мл на 100 мл воды) или 3–5%-ный раствор ЭМС-Й, вид А (1 ч. ложка на 100 мл воды). Соски необходимо погрузить в дезинфицирующий раствор на пару минут.
Важное значение имеет правильный запуск коров. За неделю до начала запуска количество сочных и концентрированных кормов необходимо снизить и коров перевести на однократное доение в течение 4–5 дней. Далее их доят через 1–2 дня и прекращают доить, когда суточный удой составит 0,5–1 кг молока. Сухостойный период составляет 60 дней, на протяжении всего этого времени обязательно следует проводить диагностику маститов.
1.2.2. Мыт лошадей
Мыт лошадей — острое инфекционное заболевание лошадей, преимущественно молодняка, характеризующееся гнойно-катаральным воспалением слизистой оболочки носоглотки и абсцессами подчелюстных лимфатических узлов.
Болеют молодые лошади, чаще от 6 мес. до 5 лет. Случаи заболевания животных старших возрастов наблюдаются редко. Источником возбудителя инфекции являются больные и переболевшие животные, а также здоровые бактерионосители. Заражение происходит чаще алиментарным и реже аэрогенным путем. Предрасполагающими факторами являются простуда, транспортировка, плохие условия содержания и др. Проявляется мыт спорадически или в виде эпизоотических вспышек. Обычно летальность не превышает 5%, однако при неблагоприятных факторах мыт может распространяться быстро, и в таких случаях летальность достигает 30–70%.
Инкубационный период длится 1–15 дней. Болезнь может протекать остро и подостро. Различают типичную и атипичную формы (метастатическая и абортивная), иногда встречается генитальная форма мыта.
Для типичной формы характерна высокая температура тела (40–41 °С), пониженный аппетит, угнетение, ринит, слизисто-гнойное истечение из носа, кашель, воспаление подчелюстных лимфатических узлов с последующим нагноением и вскрытием их. При пальпации области глотки выявляется сильная болезненность. Дыхание учащенное и сопящее. В процесс вовлекаются многие лимфатические сосуды.
При метастатическом мыте образуются абсцессы в легких и других внутренних органах и лимфоузлах, постоянно держится высокая температура, животное истощено.
Для абортивной формы характерны повышение температуры тела, ринит, незначительное увеличение подчелюстных лимфатических узлов без нагноения. Через 5–7 дней наступает выздоровление.
Генитальная форма мыта проявляется катарально-гнойным воспалением слизистой оболочки влагалища, регионарных лимфоузлов, иногда гнойным маститом. У жеребцов протекает в виде острого катарально-гнойного воспаления головки полового члена и мочеиспускательного канала.
Дифференциальный диагноз. Необходимо исключить сап, грипп лошадей. При сапе чаще наблюдают односторонние гнойные истечения из носа, обнаруживают специфические узелки и язвы на носовой перегородке. Подчелюстные лимфоузлы при сапе увеличены, плотные и не абсцедируют. Сап часто протекает при нормальной температуре тела и сохраненном аппетите.
Лечение. Больных животных немедленно изолируют в отдельное сухое, теплое помещение без сквозняков. Проводят вскрытие абсцессов и обработку раны. Применяют антибиотики (геомицин ретард, терравитин, линкомицин, кламоксил и другие внутримышечно в дозе 1 мл на 10 кг живой массы 1 раз в 3 дня); сульфаниламидные препараты (триметасул или триметазульф и др.). Внутривенно — 150–200 мл 33% спирта, приготовленного на 20–30% глюкозе с добавлением 1% норсульфазола (при метастатическом мыте).
Профилактика и меры борьбы. В целях профилактики мыта необходимо молодняк обеспечить полноценным кормлением; содержать в сухих, хорошо вентилируемых конюшнях; предоставлять ежедневный моцион; постоянно оберегать жеребят от воздействия простудных факторов (сквозняки, водопой из холодных водоисточников, пребывание под холодным дождем).
Для предотвращения возможного заноса возбудителя мыта завоз лошадей и приобретение фуража производят только из хозяйств, благополучных по данной болезни. Всех вновь поступивших лошадей содержат обособленно в профилактическом карантине 30 дней.
В случае возникновения мыта конеферму (табун) объявляют неблагополучной и накладывают ограничения. Запрещают выводить лошадей их неблагополучной фермы и вывозить фураж, перегруппировку лошадей внутри хозяйства, допуск посторонних лиц на ферму. Проводят поголовный клинический осмотр и термометрию лошадей. Больных животных изолируют и лечат, остальных ежедневно осматривают, организуют им индивидуальное содержание, кормление и водопой, проводят дезинфекцию помещений. Хозяйство объявляют благополучным и снимают ограничения через 15 дней после выздоровления последнего больного животного и проведения заключительных ветеринарно-санитарных мероприятий (поголовный клинический осмотр, заключительная дезинфекция).
1.2.3. Диплококковая септицемия молодняка
Диплококковая септицемия молодняка — инфекционная болезнь преимущественно молодняка сельскохозяйственных животных, которая проявляется признаками сепсиса.
Возбудитель — S. pneumoniae (пневмококки). Относится к семейству Streptococcaceae, роду Streptococcus, насчитывающему почти 40 видов. У новорожденных пупочную инфекцию и септическую форму преимущественно вызывает гемолитический S. zooepidermicus группы С; стрептококковую пневмонию телят и поросят — S. pneumoniae (син. Diplococcus lanceolatus); лимфадениты, артриты и абсцессы в тканях — серогруппы стрептококков С, D, Е и L. Патогенные стрептококки — неподвижные, в диаметре не менее 2 мкм, грамположительные, имеют капсулу, микроаэрофилы. Обладают факторами вирулентности (адгезины, гемолизины, гиалуронидаза, токсины). Принадлежат к слабоустойчивым во внешней среде микроорганизмам: особенно чувствительны к солнечным лучам и высушиванию. Однако возбудитель, высушенный в белковой среде (кровь, гной, мокрота), сохраняется до 2 мес., в молоке — в течение часа. Нагревание при 55 °С убивает его за 10 мин, 2%-ный раствор фенола — за 5 мин, 2%-ный раствор формальдегида и 20%-ная свежегашеная известь — за 10–15 мин. Возбудитель по устойчивости к дезсредствам относится ко 2-й группе (устойчив).
Пути заражения — алиментарный и аэрогенный. Заболевает молодняк с первых дней жизни.
Патогенез. Попав в организм, возбудитель размножается в месте внедрения, а затем разносится с током крови и лимфы. Токсины, выделяемые стрептококками, угнетают иммунную систему, вызывая иммунодефицит.
Клинические признаки и течение. Инкубационный период — 1–2 дня, иногда до недели. Болезнь протекает сверхостро, остро, подостро и хронически. Сверхострое течение (септикотоксическая форма): внезапная слабость, конъюнктивит, ринит, повышение температуры (40–42 °С), одышка, хрипы, аритмия, цианоз слизистых и перед смертью — истечение из ноздрей пенистой жидкости (отек легких). Животное погибает через несколько часов. Острое течение: гипертермия (41–42 °С), учащенный слабый пульс и дыхание, обильное слезотечение, катарально-гнойные истечения из ноздрей, отсутствие аппетита, аритмия, у новорожденных воспаляется пупочный канатик, нарастающая слабость, депрессия, гибель через 1–2 дня с признаками септицемии (септическая форма). Подострое течение: слабая лихорадка и плохой аппетит, часто остаются незамеченными. Вскоре появляются ведущие признаки поражения легких (легочная форма), суставов (суставная форма), пищеварительного тракта (кишечная форма). Возможна и смешанная форма с признаками катаральной бронхопневмонии, гастроэнтерита и воспаления суставов. Животные худеют, глаза глубоко западают в орбиты. Смерть при несвоевременном лечении — через 2–3 дня. Хроническое течение наблюдают у животных старшего возраста. Отмечается перемежающаяся лихорадка, периодическая диарея, пневмония, катарально-гнойный ринит, кашель становится частым, влажным, появляются хрипы.
Тяжесть болезни зависит от степени поражения легких.
Патолого-анатомические исследования. При сверхостром течении характерные патолого-анатомические процессы не успевают развиться. Находят лишь кровоизлияния в слизистой оболочке желудочно-кишечного тракта, брюшине, в эпи- и эндокарде.
Клиника. При остром течении в зависимости от путей заражения поражаются преимущественно дыхательная или пищеварительная системы. При аэрогенном заражении: в верхних дыхательных путях — острое катаральное воспаление, в бронхиальных и средостенных лимфоузлах — серозное воспаление, в легких — серозно-геморрагическая или крупозная пневмония, в плевре и перикарде — фибринозное воспаление. Селезенка увеличена, септическая, резиноподобной консистенции, выявляются множественные кровоизлияния в эпи- и эндокарде, в плевре, зернистая дистрофия в печени, почках и миокарде.
При алиментарном заражении поражается желудочно-кишечный тракт. В сычуге и тонком кишечнике — острое катаральное или геморрагическое воспаление. Кроме того, обнаруживают морфологические признаки сепсиса. Могут одновременно поражаться дыхательная и пищеварительная системы. При хроническом течении болезни основные патолого-анатомические процессы локализуются в легких. В них фибринозно-некротическая пневмония, которая часто осложняется серозно-фибринозным плевритом и перикардитом, обнаруживают также инкапсулированные абсцессы в легочной ткани, в уставах — серозно-фибринозное или гнойное воспаление.
Патолого-анатомическая картина. При остром течении отмечается геморрагический диатез; септическая селезенка (резиноподобная, каучуковая консистенция); серозное воспаление бронхиальных и средостенных лимфоузлов; зернистая дистрофия печени, почек, миокарда; серозно-геморрагическая или крупозная пневмония (с преимущественным поражением передних и средних долей); серозно-фибринозный плеврит и перикардит.
Для хронического течения характерны: крупозная некротическая или фибринозно-гнойная абсцедирующая пневмония; серозно-фибринозный плеврит и перикардит; серозно-фибринозные или гнойные артриты.
При диагностике стрептококковой септицемии учитывают эпизоотическую ситуацию, возраст животного, клинические признаки, патолого-анатомические изменения, результаты бактериологического исследования. Дифференцировать нужно от колибактериоза, сальмонеллеза, пастереллеза, диспепсии. При колибактериозе выражен сепсис, но нет пневмонии; при сальмонеллезе находят сепсис и сальмонеллезные узелки в печени; при пастереллезе есть крупозная пневмония, но нет септической селезенки; при диспепсии нет сепсиса.
1.2.4. Диагностика стрептококкозов
Диагностика стрептококкозов. Материал для исследования: при подозрении на мастит коров исследуют паренхимное молоко; на мыт лошадей — прижизненно исследуют носовые истечения, содержимое абсцессов лимфатических узлов (пунктат), для посмертной диагностики — кровь из сердца, кусочки печени, легких, селезенки; на септические стрептококкозы — кровь из сердца, паренхиматозные органы, костный мозг.
Лабораторная диагностика стрептококкозов основана на результатах бактериоскопического исследования, выделения чистой бактериальной культуры, биохимических, серологических исследований и биопроб.
Морфология. Микроскопия препаратов из исходного материала. Препараты окрашивают по Граму и на капсулы. Все стрептококки грамположительные, сферические или овальные клетки, диаметром 0,5–1,5 мкм, расположенные в цепочку различной длины, спор не образуют, неподвижные. Особо вирулентные штаммы образуют капсулу.
Культуральные свойства. Стрептококки — факультативные анаэробы. На обычных питательных средах растут слабо. Для культивирования используют обогащенные среды: МПА с 1% глюкозы и 5% крови барана или кролика; МПБ с 1% глюкозы и 10% инактивированной сыворотки крови лошади. Оптимальная температура роста — 37–38 °С (от 25 до 45 °С). S. agalactiae: в глюкозо-кровяном бульоне среда остается прозрачной, формирующиеся крупинки оседают на дно; на глюкозо-кровяном агаре — колонии мелкие, сероватые, просвечивающиеся с бета- или двойной зоной альфа-гемолиза. S. equi: в МПБ рост с помутнением среды и образованием хлопьевидного осадка. Через 3–5 суток культивирования бульон просветляется, на дне пробирки осаждается плотный осадок. На МПА колонии мелкие, росинчатые, слизистые, округлой формы с зоной бета-гемолиза, позднее становятся серо-белыми. S. pneumoniaе: в МПБ растет с равномерным помутнением среды; на МПА колонии круглые, полупрозрачные, плоские, с приподнятым центром и краями, с зоной альфа-гемолиза. S. pyogenes: в МПБ растет с просветлением среды и выпадением зернистого осадка; на МПА колонии мелкие, прозрачные, округлой формы, с зоной бета-гемолиза (рис. 1.2.1, 1.2.2).
Рис. 1.2.1. Streptococcus pyogenes на кровяном агаре
Биохимические свойства
Streptococcus agalactiae: не разжижает желатину, не редуцирует и не свертывает метиленовое молоко; ферментирует углеводы: лактозу, сахарозу, глюкозу, мальтозу; не ферментирует сорбит и дульцит; вызывает гидролиз гиппурата натрия. Проявляют гемолиз в условиях САМР-пробы (на кровяной агар в чашках Петри бактериологической петлей по диаметру засевают в виде полоски гемолитический стафилококк. Отступив 2–3 см, перпендикулярно к стафилококку петлей высевают штаммы исследуемых стрептококков, помещают в термостат (37 °С на 24 ч).

Рис. 1.2.2. Разные виды патогенных стрептококков: 1 — чистая культура S. agalactiae; 2 — S. equi в гное; 3 — S. pyogenes в крови (сепсис); 4 — S. pneumoniaе в патологическом материале из легких; 5 — S. pyogenes в гное; 6 — образование поперечной перегородки в делящейся клетке гемолитического стрептококка: а — образующаяся перегородка; б — нуклеоид; в — клеточная стенка
Во всех случаях выделения агалактийного стрептококка в пробах молока высокое содержание лейкоцитов, ослабление лизоцимной активности, положительная проба Уайтсайда (лейкоцитоз), положительная бромтимоловая проба на щелочность молока.
Вирулентность патогенных стрептококков обусловлена тем, что они вырабатывают токсины. Так, S. agalactiae продуцирует гемолитический, некротический лейкоцидин, эритрогенный токсин (обуславливает местную воспалительную реакцию тканей), вырабатывает ферменты фибринолизин и гиалуронидазу, усиливающие его патогенность.
S. equi: не свертывает молоко, не редуцирует лакмус и метиленовый синий, не сбраживает лактозу, сорбит, манит, что позволяет дифференцировать его от других стрептококков; не растет в присутствии мытного антивируса (фильтрат 20-дневной бульонной культуры мытного стрептококка), в то время как все остальные виды стрептококков растут.
S. pneumoniaе: ферментирует углеводы лактозу, сахарозу, глюкозу, мальтозу, салицин, инулин; не разжижает желатину, не образует индол, свертывает молоко; растворяется в желчи. Отношение к желчи и разложение инулина имеет дифференцирующее значение от других стрептококков.
Серологическая типизация выделенного стрептококка определяется в реакции кольцепреципитации с использованием преципитирующих групповых стрептококковых сывороток и суточной бульонной культуры.
Биопроба. Биопробу на стрептококкозы проводят на белых мышах с применением свежевыделенных штаммов 18–20-часовых бульонных культур. Культуру вводят трем мышам внутрибрюшинно по 0,5 мл. При гибели не менее двух мышей культуру признают патогенной.
В случае инфекции, вызванной S. pneumoniaе, проводят выделение возбудителя из исследуемого материала методом биопробы (тканевую суспензию, разведенную в стерильном физиологическом растворе в соотношении 1:2, внутрибрюшинно вводят белым мышам).
В положительных случаях мыши погибают через 1–2 сутки.
Схемы лабораторной диагностики и биопрепараты. См. приложения.
1.3. Возбудители стрептококкоза свиней
Стрептококкоз свиней чаще является главной причиной потерь подсвинков и поросят-откормочников. У поросят наиболее часто стрептококки вызывают менингит, который вызывается S. suis типа 1 и особенно типа 2. S. suis типа 1 вызывает септицемию, менингит и артрит у поросят-сосунов. Свиноматка является переносчиком инфекции, которая проникает через миндалины в организм поросят и вызывает повышение температуры, а в отдельных случаях приводит к смерти. Другие поросята того же помета могут иметь менее тяжкие клинические симптомы. Артрит, приобретенный в возрасте 5–10 дней, может проявляться впоследствии у взрослых свиней и приводит к снижению их репродуктивности. Микроб легко выделяется из организма поросят, погибших в стадии септицемии, из мозга и суставов животных с признаками менингита и артрита. S. suis типа 2 является наиболее частым виновником стрептококкового менингита у свиней. Микроб может вызвать септицемию, но основные клинические симптомы — это менингит у свиней-отъемышей до 70 кг, хотя могут быть поражены и взрослые свиньи со слабым иммунитетом. У инфицированных свиней повышается температура, «стекленеют» глаза, могут быть судороги головы или конвульсии, они погибают в течение нескольких часов или выживают, если болезнь длится несколько дней. Поражение мозга у свиней может быть длительным.
В связи с имеющейся полисахаридной оболочкой у восприимчивых (не имеющих типичных антител) животных инфекция эта охраняется от фагоцитоза, кроме прочих, определяет его болезнетворность. В настоящее время известны 35 имеющих оболочку серотипов S. suis. Часть изолированных штаммов невозможно классифицировать ни в одной группе серотипов, и это связано с отсутствием оболочки. Идентифицировано два протеина, связанные с вирулентностью S. suis типа 2. Первый высвобождается мурамидазой (MRP), и другой, который ввиду проявления только в супернатанте, назвали внеклеточным фактором (EF). Считается, что эти белки являются факторами вирулентности, играющими существенную роль в патогенезе заражения этим микроорганизмом. Если болезнь протекает с клиническими признаками, характерными для стрептококкоза, изолируются, кроме того, серотипы от 1 до 8 S. suis. Стрептококки S. suis можно изолировать также и от здоровых свиней. Результаты молекулярных исследований показывают, что в области каждого серотипа S. suis имеется целый ряд генотипов этого микроорганизма. На ферме, которой коснулась энзоотическая форма стрептококкоза, болезнетворный генотип S. suis типа 2 может одновременно иметь болезнетворные и непатогенные штаммы S. suis. Во время эпизоотии стрептококкоза на свиноферме можно изолировать одновременно от поросят оба вида этих штаммов, что может осложнить производство вакцины. Свиньи являются главным источником и вектором в распространении S. suis. Есть много восприимчивых к заражению этими микроорганизмами пород домашних и используемых свиней, а также птиц и грызунов. Из миндалин, из половой системы и кишечника здоровых животных можно изолировать ряд стрептококков. Микроорганизмы эти считаются составляющими бактериальной флоры кишечника (S. intestinalis, S. hyointestinalis, S. suis, S. alactolyticus). От даже одной здоровой особи можно иногда изолировать много серотипов стрептококка. Исследуя свиней на наличие S. suis, в 31% случаев изолирован от свиней только один серотип S. suis, в 38% — 2 или 3 серотипа и в 6% — более чем 4 серотипа. Особое внимание ученых обращено на факт изоляции S. suis от все большего числа пород животных и птиц. Это явление с уверенностью может иметь существенное значение в распространении инфекции этим микроорганизмом.
Устойчивость. Streptococcus suis имеет большие способности выживания вне организма свиней — в воде при температуре 4 °С живет в течение почти двух недель, в кале при температуре 0 °С живет до 15 недель. При комнатной температуре сохраняет инфицирующие способности до двух недель. Стрептококки очень восприимчивы ко всем обеззараживающим средствам и к детергентам. Тридцатиминутное воздействие мыла приводит к их инактивации.
Патогенез. Источником стрептококков обычно являются клинически здоровые носители этих микроорганизмов. Введение в восприимчивое к заражению стадо распространителей патогенных штаммов S. suis вызывает резкое проявление стрептококкоза, прежде всего в группах отсаженных поросят и подсвинков. Заражение новорожденных может произойти уже в первые дни и даже часы их жизни. Это происходит аэрогенным путем, а также и в результате питья поросятами инфицированного молозива или молока. Возможно заражение через родополовые пути, где он часто бытует. Воротами проникновения стрептококков в организм из зараженной среды является также пораженный эпителий слизистой оболочки полости губы новорожденных как следствие неправильного срезания клыков, в результате чего появляется местное повреждение и некроз противоположной десны. Несмотря на то что большинство отсаженных поросят инфицированы S. suis, только некоторые из них заражены штаммами, способными вызвать болезнь. Вектором в распространении стрептококкоза могут быть блохи. В организме стрептококки живут до 5 дней.
Важную роль в патогенезе играют моноциты. Выполняют они только роль «переносчика» штаммов S. suis из миндалин в мозг, суставов и сывороточных оболочек организма, но являются также формой инкубатора, в котором микроорганизмы эти могут размножаться. Эти клетки могут переносить болезнетворные штаммы, зато они не способны перемещать невирулентные штаммы. Большинство научных работ, касающихся патогенеза стрептококкоза, относятся к стрептококковому воспалению оболочек мозга. Гораздо хуже изучен патогенез очень важной актуальной проблемы, которой является воспаление легких, связанное с инфицированием подсвинков или откормочников S. suis типа 2. Доказано, что на свинофермах, инфицированных вирусом PRRS и S. Suis, число случаев стрептококкового воспаления оболочек мозга намного больше, нежели в хозяйствах, инфицированных исключительно S. suis.
Независимо от клинической формы стрептококкоза первичным местом существования стрептококков являются миндалины. Отсюда микроорганизмы попадают в периферийные лимфатические узлы, в которых могут быть задержаны, что блокирует развитие болезни, или, в случае снижения их сопротивляемости, попадают в кровь, вызывая сепсис. С кровью могут попасть в оболочки мозга, суставов, легких, сердца и иные органы. Клинические проявления стрептококкоза зависят от места, куда проникли стрептококки, а также степени повреждения инфицированных органов.
Клинические признаки. В течение стрептококкоза можно наблюдать очень разные клинические симптомы, связанные с воспалением оболочек мозга, легких, суставов, слизистых оболочек, детородных путей, сердечной мышцы и с септицемией и околобронхиальным воспалением легких. Клинические симптомы болезни наблюдаются у свиней разного возраста, как у недельных поросят, так и у 70-килограммовых откормочников, и даже у свиноматок. При острой форме стрептококкоза ее течение может быть бессимптомным, а единственным симптомом проявления болезни в стаде являются внезапный падеж отсаженных подсвинков или откормочников. Температура тела повышается до 42,5 °С.
В практике вызывающими подозрение признаками являются поражения и конвульсии, связанные с воспалением оболочек мозга. При визуальном наблюдении стада можно заметить нарушение координации движений, в том числе «забрасывание зада», нарушение естественного поведения, отставание поросят от группы, потерю аппетита и связанное с этим похудение (рис. 1.3.1).
При суставной форме стрептококкоза спустя несколько дней обнаруживается наличие лежащих на боку поросят, выполняющих конечностями весельные движения; иногда из пасти выделяется пенистая слюна, а у некоторых поросят наблюдается нистагм. Последствием укрепления стрептококка в суставах являются воспалительные признаки, проявляющиеся в отеке и связанной с этим хромоте. У свиноматок S. suis бывает причиной выкидышей или воспалительных изменений во влагалище, что проявляется в виде слизистых выделений. S. suis может быть причиной сниженной даже до 15% результативности покрытия, рождения мертвых плодов и резкого падежа поросят в первые 24 ч жизни.
Streptococcus suis вызывает воспаление перикарда, его последствием является падеж откормочников с признаками цианоза. В Польше S. suis все чаще является причиной воспалительных изменений в легких, главным образом у свиней с массой тела 20–60 кг. Ввиду диагностических трудностей фактор болезни не всегда бывает обнаружен. Интересно, что в Великобритании стрептококкоз связывают прежде всего с сепсисом, воспалением оболочек мозга, воспалением суставов и редко с воспалением легких, в то время как в США и Голландии S. suis считают главным этиологическим фактором воспаления легких и только потом причиной воспаления оболочек мозга, воспаления эндокарда и суставов.
Патолого-анатомические изменения. К изменениям, характерным для стрептококкоза у свиней, относятся: увеличение бронхиальных лимфатических узлов, брыжейки и селезенки; гиперемия и заметно налитые кровеносные сосуды оболочек мозга; увеличенное количество мозговой жидкости. Типичным является фибринозно-гнойное воспаление перикарда, который иногда полностью покрыт фибрином. В сумке перикарда и в грудной клетке обнаруживается большое количество сывороточной выпотной жидкости. В легких отмечается долечное воспаление легких и часто фибринозное воспаление плевры. Характерной чертой также является наличие транссудата и отложение фибрина между петлями кишечника. Могут произойти воспалительные изменения суставов конечностей.

Рис. 1.3.1. Стрептококковый менингит (S. suis типа 2): а — типичное положение головы при стрептококковом менингите поросят; б — поросята-сосуны с нарушениями деятельности головного мозга вследствие гнойного менингита, вызванного стрептококковой инфекцией; в — живой инфицированный подсвинок, отчетливо виден опистотонус и плавательные движения передних конечностей; такие движения зачастую ведут к повреждению кожи и костей; г — головной мозг с гнойным налетом на мозговых оболочках, вызванным стрептококковой инфекцией
Меры профилактики. В инфицированных S. suis типа 2 стадах риск всплеска болезни увеличивается вместе с частым воздействием стрессовых факторов; неправильным обрезанием клыков; шероховатой поверхностью полов, на которой находятся поросята; слабой молочностью свиноматки и связанной с этим борьбой поросят-сосунов за «хорошее место» при молочной железе; скученным содержанием в станках; частыми перемещениями и смешиванием разных групп свиней; появлением в стаде вируса РРСС; несоблюдением зоогигиенических требований (плохой системой вентиляции и освещенности, высокой влажностью и запыленностью и др.); необоснованной и резкой сменой корма; нехваткой витаминов Е и селена.
Общая схема лабораторной диагностики и биопрепараты. См. приложения.
[1] Роберт Кох — немецкий микробиолог. Открыл бациллу сибирской язвы, холерный вибрион и туберкулезную палочку. В 1890 г. изготовил туберкулин. За исследования туберкулеза в 1905 г. награжден Нобелевской премией по физиологии и медицине.
Глава 2. ГРАМПОЛОЖИТЕЛЬНЫЕ БАКТЕРИИ, НЕ ОБРАЗУЮЩИЕ СПОР
2.1. Возбудители туберкулеза
Туберкулез — хроническое инфекционное заболевание сельскохозяйственных и диких животных, птиц, а также человека, характеризующееся образованием в пораженных тканях и органах специфических бугорков (туберкулов), предрасположенных к творожистому распаду. Наиболее восприимчивы к туберкулезу крупный рогатый скот, свиньи и куры.
В последние годы в России отмечен рост туберкулезе среди населения.
В настоящее время Россия входит в первую десятку наиболее неблагополучных стран.
Возбудитель выделен в 1882 г. Р. Кохом.
Возбудители туберкулеза относятся к роду Mycobacterium, семейству Mycobacteriaceae. Различают следующие основные виды возбудителя туберкулеза: М. tuberculosis — возбудитель туберкулеза человека; М. bovis — возбудитель туберкулеза крупного рогатого скота; М. avium — возбудитель туберкулеза птиц; M. murium — вид возбудителя туберкулеза мышей-полевок; М. poykilothermorum — вид возбудителя туберкулеза холоднокровных. В патологии животных и человека участвуют первые три вида возбудителей туберкулеза.
Атипичные микобактерии. Наряду с истинными возбудителями туберкулеза в природе встречаются атипичные, что обуславливает их попадание в организм животных. Различают четыре группы атипичных микобактерий (по Е. Раньон, 1959):
1. Фотохромогенные, приобретающие на свету темно-оранжевую окраску. В темноте не образуют пигмент (М. kansassii).
2. Фотохромогенные, приобретающие ярко-оранжевую окраску независимо от выращивания на свету или в темноте (М. scrofulaceum, M. Gordonae, M. Aquae и др.).
3. Нефотохромогенные — могут быть неокрашенными или иметь желтовато-оранжевые оттенки. Пигментация не зависит от экспозиции на свету (М. intracellulare, M. Battey).
4. Быстрорастущие — образуют колонии в течение недели при 25 и 37 °С (M. phlei, M. smegmatis, M. fortultum).
Морфология. Виды микобактерий туберкулеза отличаются по морфологическим и культуральным свойствам. M. tuberculosis — тонкая, нежная, слегка изогнутая палочка; M. bovis — толще и короче, чем M. tuberculosis; M. avium — короче по сравнению с M. tuberculosis и M. bovis и более полиморфна. В электронном микроскопе микобактерии всех видов имеют вид палочки с закругленными концами.
Размеры и формы микобактерий могут иногда варьировать в зависимости от питательной среды, условий культивирования, возраста культуры.
В последние годы часто выделяют атипичные L-формы возбудителя туберкулеза. Это измененные формы, которые выделяют в виде мелких зерен, шаровидных тел. L-формы обладают способностью к реверсии (т. е. переходить в типичные, патогенные формы, вызывающие заболевания).
Микобактерии туберкулеза спор и капсул не образуют, неподвижны, аэробы. Высокая устойчивость микобактерий во внешней среде обусловлена тем, что они относятся к группе кислото-спирто-щелочеустойчивых, которые содержат в своем составе жировосковые вещества и миколовую кислоту (до 60%). В цитоплазме располагаются кислотолабильные гранулы, состоящие в основном из метафосфата (зерна Муха). Липиды и воскоподобные вещества придают микробной клетке гидрофобность, т. е. способность отталкивать воду и водные растворы красителей, кислот, щелочей, в связи с чем бактерии туберкулеза плохо воспринимают окраску.
Диагностика
Материал для исследования. Для прижизненной диагностики: истечения из носа, бронхиальная слизь, молоко, сперма, фекалии, моча.
Для посмертной диагностики: труп птиц целиком (исследуют печень, селезенку, легкие, яичники). От крупных животных — кусочки пораженных тканей и органов с туберкулами, лимфатические узлы. Материал свежий, замороженный, или в 30%-ном глицерине.
Обсемененность патологического материала микобактериями туберкулеза может быть незначительной, поэтому для получения достоверных диагностических результатов специальными методами обработки повышают концентрацию возбудителя. К обработке предъявляют ряд требований: она должна обеспечивать гомогенизацию материала, уничтожать сопутствующую микрофлору, быть щадящей для микобактерий туберкулеза и способствовать их концентрации в материале (обогащение). Обогащение проводят в зависимости от исследуемого материала.
• Мокрота, слизь, гной — заливают равным объемом трехзамещенного фосфата натрия (на 24 ч в термостат). Центрифугируют при 3000 об/мин 10–15 мин. Исследуют осадок.
• Пораженные ткани — готовят гомогенат, заливают 3–10%-ным раствором H2SO4 (1:4). Центрифугируют при 3000 об/мин 10–15 мин. Отмывают физиологическим раствором. Исследуют осадок.
• Молоко — 150 мл. Центрифугируют при 3000 об/мин 20–30 мин. Осадок обрабатывают 3–6%-ным раствором H2SO4 20–30 мин. Центрифугируют, исследуют осадок.
• Масло (2–4 г) — в стерильную пробирку. Залить горячей водой, встряхивать 5–10 мин. Перевернуть, охладить. Исследовать жидкость, как молоко.
• Фекалии (50 г) — растирают в 18%-ном растворе Н2SО4, фильтруют через марлю, центрифугируют. Исследуют осадок.
Для концентрации микобактерий в исследуемом материале применяют также метод флотации. В колбу с узким горлом вносят 10 мл гомогената + 10 мл 1%-ного NaOH, шуттилируют 10 мин. Затем + дистиллированную воду (1:9) + 1–2 мл ксилола (бензина, петролейного эфира), шуттилируют 10 минут + еще дистиллированную воду до горлышка. Через 30 мин исследуют содержимое флотационного кольца.
Лабораторная диагностика туберкулеза основана на результатах бактериологического, аллергического и серологического исследований.
Бактериологическое исследование включает в себя обнаружение возбудителя в исходном материале (методами световой и люминесцентной микроскопии и биопробы), выделение чистой культуры и идентификацию возбудителя по культурально-морфологическим, ферментативным и патогенным признакам.
Бактериоскопия препаратов из исходного материала. Из-за специфического состава (30,0–40,0% липиды) микобактерии туберкулеза не окрашиваются обычными методами, но хорошо воспринимают краску после обработки карболовым фуксином при подогревании. Их красят специальным методом — по Цилю — Нильсену: добавляют карболовый фуксин (при подогревании), промывают водой, затем обесцвечивают мазок 5%-ным раствором серной кислоты (2 минуты) и снова промывают водой, проводят дополнительно обесцвечивание 70–90%-ным этиловым спиртом (3–5 с), докрашивают раствором метиленовой сини (или малахитовой зелени)
Микроскопическая картина: микобактерии окрашиваются в ярко-красный цвет, остальная микрофлора — в синий или в зеленый (рис. 2.1.1).
При окрашивании по Граму применяют модифицированный метод Грама — Мухи: на фиксированный мазок вносят карболовый метилвиолет (красят при подогревании), затем на 1 мин вносят раствор Люголя и обесцвечивают 5%-ной азотной кислотой (либо 3%-ной соляной кислотой, либо смесью ацетона и спирта), затем докрашивают сафранином или разведенный фуксином.

Рис. 2.1.1. Микобактерии туберкулеза. Окраска по Цилю — Нильсену
Микроскопическая картина: микобактерии фиолетового цвета, остальные микроорганизмы — красного цвета.
Бактериоскопический метод позволяет выявить возбудителя при концентрации микобактерий (1–5) × 105/мл. Более результативна люминесцентная микроскопия (окраска аурамин-родамином), благодаря которой выявляют даже незначительное количество микобактерий, которые окрашены в бело-желтый цвет, а также формы с измененными тинкториальными свойствами.
Культуральные свойства. Возбудитель туберкулеза — строгий аэроб. Оптимальная температура для M. tuberculosis — 37–38 °C, M. bovis — 38–39 °C, M. avium — 39–41 °С. Оптимум рН среды — 6,8–7,4.
Растут медленно. Для культивирования микобактерий туберкулеза используют сложные питательные среды, содержащие глицерин, картофель, яйца, витамины. Рост бактерий стимулируют аспарагиновая кислота, альбумин, глюкоза, биотин, никотиновая кислота, соли аммония и др. Наиболее часто применяют среды Петраньяни, Левенштейна — Йенсена, Гельберга.
M. tuberculosis — на жидких средах к концу месяца образуется толстая морщинистая пленка (рис. 2.1.2). На плотных питательных средах — рост в виде сухого морщинистого налета кремового цвета. У колоний приподнятый центр, они крошковидные, с приятным запахом, по виду напоминают цветную капусту, плохо смачиваются водой.
На жидких средах при внутриклеточном развитии для M. tuberculosis характерно образование корд-фактора (трегалоза 6,6-дипилокат), способствующего сближению бактериальных клеток в микроколониях в виде серпантинообразных «кос» (рис. 2.1.3).
M. bovis — на жидких средах через 20–60 дней образуется пленка: вначале в виде единичных островков, которые затем сливаются в сплошную петлистую, бородавчатую пленку. На плотных средах — колонии мелкие, гладкие, цвета слоновой кости, иногда с морщинистым сероватым налетом.
M. avium — на жидких средах через 10–20 дней сначала образуется тонкая, нежная пленка, которая затем становится слегка морщинистой, влажной, жирной, образуется небольшой рыхлый осадок. На плотных яичных средах — колонии округлые, слизистые, мягкие, серовато-белые, маслянистые, с возрастом желтеют, иногда образуют возвышение с кратерообразным углублением.

Рис. 2.1.2. Рост M. tuberculosis на плотной и жидкой питательной среде
M. tuberculosis — патогенны для человека, крупного рогатого скота, свиней, собак, кошек. Из лабораторных животных восприимчивы кролики, морские свинки.
M. bovis — патогенны для крупного рогатого скота, овец, коз, свиней, лошадей, кошек, собак, оленей, маралов и др. Из лабораторных животных восприимчивы кролики, морские свинки. Восприимчив человек.

Рис. 2.1.3. Серпантинообразные «косы» из микобактерий туберкулеза (корд-фактор)
M. avium — вызывает туберкулез кур, индеек, цесарок, фазанов, павлинов, голубей, уток и других птиц. Также к нему восприимчивы свиньи, лошади, козы, овцы и иногда крупный рогатый скот и человек. Из лабораторных животных чувствительны кролики. Для биопробы от птиц используют кур.
Биопроба. Метод применяют не только для обнаружения возбудителя в исследуемом материале (рис. 2.1.4), но и для определения его видовой принадлежности.
Заражают: двух морских свинок — по 1–2 мл суспензии материала подкожно в область паха; двух кроликов — внутривенно; двух кур внутривенно (морских свинок и кур — после туберкулинизации!). Наблюдают 3 мес. При положительном результате у морских свинок через 2–3 недели увеличиваются регионарные лимфоузлы, на месте инъекции образуется уплотнение, затем язва. Через 30 дней морскую свинку туберкулинизируют. При положительной реакции подвергают убою и бактериологическому исследованию. При обнаружении в мазках микобактерий дают положительное заключение и дальнейшее биологическое исследование прекращают.

Рис. 2.1.4. Биопроба на туберкулез
Вид микобактерий устанавливают по результатам биопробы (табл. 2.1.1).
Таблица 2.1.1
Патогенность микобактерий туберкулеза для лабораторных животных

Серологическая диагностика. Постановку РСК (реакции связывания комплемента) рекомендуют как дополнительный метод при отборе для диагностического убоя животных, положительно реагирующих на туберкулин.
Аллергическая диагностика. Не принадлежит к лабораторным методам, но на практике является основным методом прижизненного определения инфекции у животных, в том числе у птиц (рис. 2.1.5).

Рис. 2.1.5. Положительная внутрикожная реакция на туберкулин: а — крупный рогатый скот; б — свиньи; в — куры
Применяют сухой очищенный туберкулин ППД (протеин пурифиед дериват), который вводят крупному рогатому скоту — буйволам, верблюдам, оленям — в толщу кожи в области средней трети шеи, свиньям — на наружную поверхность уха, курам — в толщу кожи бородки.
У крупного рогатого скота, буйволов, верблюдов, оленей реакцию учитывают через 72 ч, измеряя толщину кожной складки с учетом припухлости. Положительной реакцией считают тестоватый отек кожи размерами 35 × 45 мм и более. Кожная складка увеличивается на 3 мм и более. Для измерения кожной складки используют кутиметр.
У свиней учет реакции через 48 ч — большая болезненная припухлость на месте инъекции туберкулина. У кур реакцию учитывают через 30–36 ч — при положительной реакции бородка опухает, становится горячей.
Крупным животным проводится внутриглазная туберкулиновая проба. Туберкулин (3–4 капли) вводится в область внутреннего угла глаза. Учет реакции через 6–12 ч. Положительная реакция — гнойный кератоконъюнктивит (рис. 2.1.6).
Аллергическая диагностика позволяет поставить диагноз в начальной стадии развития болезни. При положительной повторной аллергической реакции животных сдают на специфический убой на мясокомбинат.

Рис. 2.1.6. Положительная внутриглазная проба на туберкулин: а — крупный рогатый скот; б — коза; в — верблюд
Симультанная аллергическая проба на туберкулез. Симультанная аллергическая проба с применением туберкулина и комплексного аллергена из атипичных микобактерий (КАМ). Применяют для диагностики туберкулеза у крупного рогатого скота при первичной постановке диагноза, а также для контроля за благополучием животных по туберкулезу в хозяйствах, где реакции на туберкулин обусловлены сенсибилизацией атипичными микобактериями. Проба является групповой и дает возможность ориентироваться в ситуации по туберкулезу лишь в целом по стаду или группе (не менее 6 голов) исследуемых животных.
Проба заключается в одновременном (симультанном) введении животным двух аллергенов: ППД-туберкулина для млекопитающих в стандартном растворе и комплексного аллергена из атипичных микобактерий (КАМ) и определении достоверности различия в интенсивности 12 (степени проявления) реакций на эти аллергены.
Под достоверностью различия понимают такое различие в величине показателей интенсивности реакций на туберкулин и КАМ, которое дает возможность с уверенностью не менее чем на 95% сделать заключение о состоянии по туберкулезу исследуемой группы животных.
Ее можно проводить не ранее, чем через 30 дней после последней туберкулинизации животных.
Туберкулин и КАМ вводят, соответственно, с левой и правой стороны тела животных строго симметрично в дозе по 0,2 мл: крс (кроме быков) — внутрикожно в середине шеи, быкам — также внутрикожно в левую и правую подхвостовую складки.
Учет и оценку реакций на туберкулин и КАМ проводят у крупного рогатого скота через 72 ч после инъекции аллергенов.
Реакцией считают припухлость в месте введения препарата, ощутимую при пальпации, независимо от ее характера (консистенции, температуры, болезненности и т. п.). При учете реакции у каждого исследуемого животного пальпируют место введения туберкулина. В случае обнаружения припухлости в месте его инъекции у этого животного прощупывают место введения КАМа и проводят измерение утолщения кожной складки. Более выраженную реакцию на туберкулин при менее выраженной или отсутствующей на КАМ обозначают знаком «+» (плюс), менее выраженную реакцию на туберкулин — знаком «–» (минус), при одинаковых реакциях — знаком «=» (равенство). Животных, не реагирующих на туберкулин, не учитывают, независимо от наличия или отсутствия у них реакций на КАМ.
Результаты оценки реакции на туберкулин в сравнении с реакцией на КАМ в знаках («+», «–», «=») записывают в ведомость учета симультанной пробы (табл. 2.1.2) и с помощью табл. 2.1.3 определяют достоверность различия в интенсивности реакций у животных на туберкулин и КАМ в целом по группе.
По ведомости подсчитывают общее количество животных, реагирующих на туберкулин с оценкой реакций «+ –» и «–» (животных, реагирующих на аллергены в равной степени, в расчет не берут), и таким образом определяют показатель А в табл. 2.1.3 (например, 14). Затем подсчитывают отдельно количество знаков «+» и знаков «–» и по табл. 2.1.3 сравнивают поочередно результаты с показателем Б, соответствующим установленному показателю А (в примере соответствующий показатель Б равен 12). Если количество знаков «+» равно или больше показателя Б, а также если при проведении пробы вообще не выявлено животных, реагирующих на КАМ, то это означает, что реакции на туберкулин выражены достоверно интенсивнее, чем на КАМ, и указывает на заражение животных возбудителем туберкулеза.
Если количество знаков «–» равно или больше показателя Б, значит, у животных реакции достоверно более выражены на КАМ. Если при этом у всех реагирующих на туберкулин животных реакции интенсивнее выражены на КАМ и получены отрицательные результаты бактериологических исследований, группу скота считают благополучной по туберкулезу. Также благополучным по туберкулезу считают поголовье животных, среди которых при проведении симультанной пробы не выявлено реагирующих на туберкулин.
Могут быть случаи, когда при достоверно более интенсивной реакции на КАМ в целом по стаду (группе) у отдельных животных наблюдаются реакции на туберкулин при менее выраженной или совсем отсутствующей реакции на КАМ. Это может быть обусловлено парадоксальным проявлением реакций на аллергены или наличием туберкулезной инфекции на фоне сенсибилизации животных к туберкулину атипичными микобактериями. Для уточнения диагноза всех таких животных, а также реагирующих в равной степени на туберкулин и КАМ (при утолщении кожной складки на 3 мм и более) обязательно подвергают убою с патолого-анатомическим исследованием на туберкулез. При отсутствии характерных изменении проводят бактериологическое исследование и в случае получения отрицательного результата стадо (группу) животных считают благополучным но туберкулезу.
Под достоверностью понимают степень различия и проявления реакций на туберкулин и КАМ, которая дает возможность с уверенностью не менее 95% сделать заключение о состоянии по туберкулезу исследуемой группы животных.
Достоверно большая интенсивность реакции на туберкулин указывает на заражение животных туберкулезом соответствующего им вида (млекопитающих — возбудителем туберкулеза бычьего или человеческого, птиц — птичьего вида); при достоверно более выраженной реакции на КАМ реакции на туберкулин считают обусловленными другими причинами.
При отсутствии достоверности различия в интенсивности реакций на туберкулин и КАМ результаты симультанной пробы считают неопределенными. В этом случае часть животных, реагирующих в большей степени на туберкулин, подвергают убою и исследованию на туберкулез. Окончательное заключение о состоянии стада или группы животных по туберкулезу делают по результатам патолого-анатомического или лабораторного исследований.
В некоторых хозяйствах возможно инфицирование животных туберкулезными и нетуберкулезными микобактериями. В этом случае при достоверно более интенсивной реакции на КАМ в целом по стаду (группе) у отдельных животных могут наблюдаться реакции на туберкулин при менее выраженных или совсем отсутствующих реакциях на КАМ. Для уточнения диагноза такие животные подлежат убою и исследованию на туберкулез.
Окончательное заключение о состоянии стада или группы животных по туберкулезу делают по результатам патолого-анатомического или лабораторного исследований.
Таблица 2.1.2
Ведомость учета симультанной пробы


Примеры пользования ведомостью учета симультанной пробы и таблицей определения различия реакций на туберкулин и КАМ у животных.
Таблица 2.1.3
Определение различия реакций на туберкулин и КАМ у животных


В ведомости, в верхней ее, части представлен пример учета результатов исследования животных, у которых оценка реакции проводится по утолщению кожной складки в миллиметрах (крупный рогатый скот, кроме быков и волов), в нижней части — по степени припухлости «+» в месте введения аллергенов (быки, волы, овцы, козы, куры). В правой графе указывается результат сравнительной оценки интенсивности реакций на туберкулин и КАМ у исследуемых животных, обозначенный знаками «+», «–» или «=», выражающими, соответственно, большую, меньшую или равную степень реакции на туберкулин по сравнению с реакцией на КАМ. Количество плюсов и минусов используют при определении достоверности различия в интенсивности реакций по таблице.
Как было указано выше, при определении достоверности различия в интенсивности реакций на аллергены животных, не реагирующих на туберкулин, не учитывают. Не подлежат также учету животные с равными реакциями на оба аллергена. Таким образом, в примере, приведенном в верхней части ведомости, имеются лишь 17 животных с отличающимися реакциями («+» или «–»). Из этого числа подсчитывают большее количество животных с одинаковым результатом сравнения реакций («+» или «–»). В данном случае больше животных (14), реагирующих на туберкулин интенсивнее (обозначены знаком «+»), чем на КАМ. Согласно таблице (приложение 2), различие в интенсивности реакций при учете ее у 17 животных (первая графа таблицы) достоверно при условии, если не менее 13 из них (вторая графа таблицы) имеют о
...